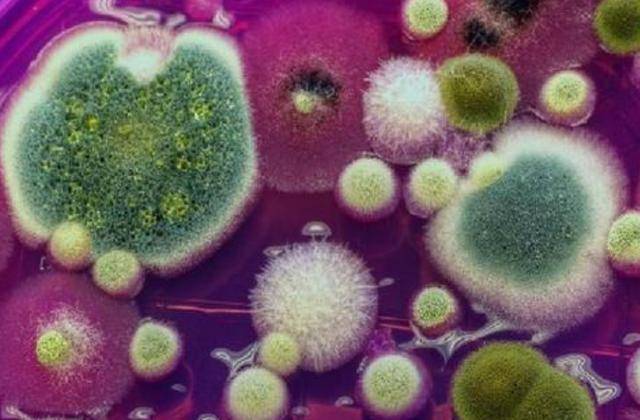

张阿姨今年刚过58岁,是家里的“零食达人”。晚饭后坐在沙发上磕瓜子,成了她每天最放松的时刻。可是,最近小区里传来“瓜子吃多了容易得癌”这种说法,把她吓了一跳。家长里短议论成一锅粥。有人说瓜子含致癌物,有人认为这都是“危言耸听”,还有人光顾着剥壳干脆啥也不信。到底瓜子是不是肿瘤的“加速器”?哪些吃法才真有风险?张阿姨就这样陷入了纠结:难道要告别这份味蕾上的慰藉?今天我们就帮大家解开这个悬案,建议每一位爱磕瓜子的朋友都认真看完,很多人一直忽视的第2点,可能才是真正的健康隐患。
瓜子到底能不能吃?长期大量食用有风险吗?医生和专家怎么看?
瓜子作为家中常见的零食,尤其在中老年人中备受欢迎。事实上,瓜子富含不饱和脂肪酸、维生素E、矿物质等,有助于调节血脂、保护心脑血管。但瓜子的健康风险并不在天然营养成分本身,而在于其加工、储存及食用方式。近年来,北京协和医院、国家食品安全风险评估中心等权威机构的报告指出,市售瓜子中最常见的健康隐患主要集中在。高盐、高油和霉变三个方面。

研究显示,高盐瓜子每100克含钠量高达1800毫克,超过国家建议每日钠摄入量(2000毫克)的90%。而过量摄入钠盐已被反复证实与高血压、心脑血管疾病乃至胃癌风险增长相关。此外,瓜子在高温炒制或反复加热过程中,容易产生苯并芘等致癌物。发霉的瓜子则易产生黄曲霉毒素,被世界卫生组织(WHO)列为“一级致癌物”。这些隐患不是个案,有数据显示,2023年我国市场抽检中13.2%的散装瓜子存在霉变、黄曲霉毒素超标等问题。看来,不是瓜子本身可怕,而是“怎么挑”和“怎么吃”才决定安危。
那么,长期吃瓜子的危害到底有哪些?身体会有哪些不良变化?尤其是哪几类瓜子,该坚决避开呢?
坚持每天大量吃瓜子的人群,高钠高油摄入容易导致“上火”、口腔溃疡、牙龈炎等小问题,但更致命的危害往往被低估:
肿瘤风险提升
摄入黄曲霉毒素含量超过标准2倍的霉变瓜子,其致癌率提升23.6%。专家指出,长期少量累积的黄曲霉毒素,极易诱发肝癌。黄曲霉毒素在湿热储存条件下生成更快,农村及无包装市场风险更高。

心脑血管负担加重
高盐瓜子会使收缩压升高8-10 mmHg,对于本身患有高血压、冠心病的中老年人尤为不利。心血管专家提醒,摄盐过多是脑卒中、心梗的隐形推手。
肝肾解毒压力增加
长时间食用调味瓜子,其中含有防腐剂、甜味剂和人工色素,这些成分需通过肝脏分解、肾脏排泄。慢性高负荷可诱发非酒精性脂肪肝、肾脏慢性损伤,特别是本身代谢能力下降的人群风险更高。
医生和膳食专家一致提醒,下面这3种瓜子再馋也别买、别吃:霉变瓜子:色泽暗淡、表面有粉末或异味,一定坚决丢弃,因为黄曲霉毒素隐患极大。五香、焦糖等调味瓜子:大多添加大量食盐、糖及多种香精色素,不仅升高血压负担,糖分摄入过量还可引发血糖波动。散装无包装瓜子:流通环节难以把控,存储标准不一,霉菌和重金属残留超标概率高,最好选择有品牌、有防伪二维码的合格产品。
那是不是就不能碰瓜子了?其实,正确吃法照样能享受健康!
医生建议,适量、正确挑选与科学储存,可以充分利用瓜子的营养价值而大幅降低健康风险。具体做到:每日建议量:约15-20克,等于一小把,分为2-3次慢慢食用。暴饮暴食最伤肠胃。优先选择原味、密封包装、知名品牌的瓜子。拒绝发潮、有异味瓜子,发现异常及时丢弃。储存瓜子须避光、干燥、防潮,高温天气请放入密封罐并远离厨房油烟。患有高血压、糖尿病人群,尤其要减少调味瓜子的摄入。搭配温热水或无糖花茶,平衡油脂摄入不腻口,还可减少对肝脏负担。

总之,健康其实就在每天的小选择中。瓜子虽小,却考验智慧。不必对瓜子“谈癌色变”,但也不能忽视其中暗藏的隐患。合理挑选、科学食用,既能满足口福,也能守住健康底线。如果担心自身健康问题,建议咨询专业医生,并进行必要的个性化饮食指导,切忌道听途说自行断定。健康维护无法依赖单一食物或一时改变,更需要持之以恒的好习惯和科学生活方式。毕竟,瓜子是佐茶、不是主食,更不可替代药物或正餐。

【免责声明】本文为健康知识科普,结合权威资料和个人观点撰写,部分情节为方便表达和阅读理解进行了适当虚构与润色,内容仅供参考,不能替代医生诊断。如感不适,请及时就医。
参考资料:
《中国食物成分表(第六版)》
《黄曲霉毒素暴露与肝癌风险关联研究进展》,中华肝脏病杂志,2021
《2022年国家食品安全风险监测报告》
北京协和医院营养科官方科普资料
《食盐摄入与高血压的流行病学证据》,中华高血压杂志,2020





